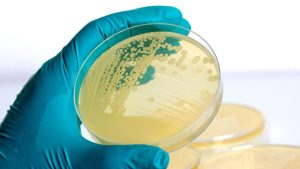

Emtek P100 portable Air Samples
The Emtek P100 is a battery operated microbial air sampler which fully complies to the requirements for Biocontamination Control of cleanrooms and associated controlled environments as specified in ISO 14698-1.
The sampler allows for capture and storage of key parameters from 500 sample runs, offering unique 21 CFR Part 11 regulatory compliant data control with data run review/deletion capabilities controlled by a system administrator. Data may be output/viewed through on optional custom label printer, USB stick, or via optional PC based software.
Flexibility
The P100 has been designed to work on two different flowrates. The high flowrate (100 LPM) is the recommended flowrate to quickly take grab samples of 1000 liter according to the microbial environmental monitoring program as required according to GMP regulations for sterile manufacturing. The monitoring program should be documented in the contamination control strategy (CCS) within the company. The lower flowrate (28,3 LPM = 1 CFM) is the recommended flowrate for real-time monitoring applications. During operation the LCD-displays key sample run information, as well as a visual sample progress indicator. The flow is controlled through a proprietary CPU-control system, which offers automated flow control.
Unique features
Flow alarm settings are available for the flow rates, which will produce both an audible and visual alarm during operation and may be output to the optional printer upon completion/termination of the sample period. The P100 operates with separate sieve impaction inlet covers for each of the two flow rates. The inlet covers include a 300-hole pattern with appropriate inlet hole sizing for each flow rate to assure a d50-value < 1µm and the optimal physical and biological recovery capabilities. The physical and biological efficiency are tested by an independent laboratory.
The P100 uses standard 90mm agar based microbial test plates (e.g., Trypticase Soy Agar,TSA). During testing the sampled air volume drawn through each air sampler is HEPA filtered before being exhausted within the P100. Sample runs on the P100 can be initiated through either the P100 touch screen Run Display screen, the supplied Infrared Remote (IR Remote), or by remote PC operation (optional). The software also allows for interval sampling to monitor an extended period of time without the need to exchange the petri-dish.
The P100 has a lengthy battery life with 6-12 hours of operation, dependent on the flow rate (6hrs @ 100 LPM) or 12 hrs @28.3 LPM). The device is lightweight and very portable, and its enclosure of Kydex ® with Microban ® (an anti-microbial agent), minimizes transfer of viable contaminants.

Compressed gas sampling and remote sampling
The P100 standard package includes a custom component carrying case, IR Remote (5-Channel), AC/DC Power Supplier/Charger, & USB Sticks (2). Optional accessories include a portable Thermal Paper/Label Printer, Horizontal Flow Inlet, Confined Space Inlet Adapter, a Compressed Air/Gas Sampling Kit and a direct impact remote air sampler (RAS) specifically designed for microbial sampling of ISO-5 environments (GMP grade A/B).

features
- DUAL flowrate design, 1 CFM or 100 LPM
- Third party validated
- Compliance to ISO 14698-1
- Anti-bacterial Microban® housing
- IQ/OQ validation protocol available
- Direct remote sampling with RAS
- Compatible with High Pressure Diffuser
- Compressed Gas Sampling to ISO-8573
- Free controller software
- HEPA filtered Exhaust